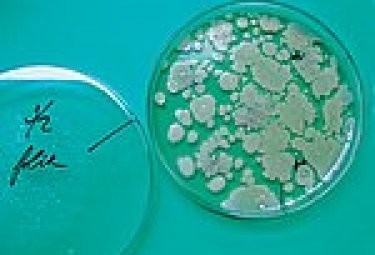

Kovový nábytek nejen do kanceláří
Firma LASTE, s.r.o., která je prodejcem předního evropského výrobce kovového nábytku BISLEY pro Českou republiku, dodává kartotéky, lístkovnice, registratury, dvoudveřové skříně,…

Firma LASTE, s.r.o., která je prodejcem předního evropského výrobce kovového nábytku BISLEY pro Českou republiku, dodává kartotéky, lístkovnice, registratury, dvoudveřové skříně,…

Spotřeba energie je faktor, který stále více nabývá na významu při celkovém hodnocení budov. Je potřeba si uvědomit, že vedle obvyklých záruk ve vztahu k bezpečnosti, zdraví a…
České spory o nájemné jsou klasickou ukázkou polovičatého řešení problému. Nebo je také možné, že jde o spory pouze naoko, které mají naopak zachovat stávající (podle mne špatný)…

Společnost Rigips, s.r.o., nabízí na českém trhu řešení oddělení bytů a všech dalších prostorů se zvýšenými nároky na ochranu majetku – bezpečnostní příčky Duragips se zvýšenou…

V začátcích činnosti malá stolařská dílna, v současné době významný výrobce dřevěných eurooken a vstupních a interiérových dveří v Čechách. V nabídce společnosti Janošík Jiří s.r…

Společnost Hörmann přichází na trh s novými garážovými ocelovými vraty, která jsou nejen odolná, ale zároveň designově atraktivní díky povrchu se strukturou dřeva. Ocelová vrata…

Hlavní výrobní sortiment společnosti VIKAM PRAHA, a.s. tvoří trapézové plechy a příslušenství. Plechy jsou vyráběny z ocelového plechu o tloušťkách 0,55 mm až 1,25 mm. Plechy s…

snadná aplikace vyplňování dutin montáže oken a dveří zvuková a tepelná izolace po vytvrzení řezatelná a přetíratelná

Oblast geodetických služeb a geodat se sice na jedné straně může jevit jako poměrně úzká, z jiného úhlu pohledu však obsahuje natolik širokou škálu služeb, že řada zákazníků a…

Firma XANADU a.s. dodává na český trh vyspělý CAD systém. Autodesk Revit Building nabízí české prostředí včetně rozsáhlé knihovny stavebních prvků dle platných českých norem.…

„Potřebujeme nasnímat scény prostorových objektů a tyto převést do přesného 3-D modelu.“ Také jste se setkali s podobným požadavkem? Pokud ano, pak Vás bude zajímat tento článek.…

Ze strany stavebních dozorů je vyvíjen stále silnější tlak na dodržování bezpečnostních předpisů na stavbách. U pažení výkopů to znamená, že výkop rýh a jam se strmými stěnami…

Ve výrobním sortimentu akciové společnosti Sedlecký kaolin jsou i materiály pro stavebnictví - omítkové směsi, malířské nátěry a fasádní barvy. Tyto výrobky jsou určeny jak pro…

Firma Likov Lipůvka spol. s r.o. působí na trhu již od roku 1994. Během této doby se vypracovala z celkem malé firmy na podnik, který se výrazným způsobem podílí na výrobě a…

Tepelná ochrana staveb je pojem, který neodmyslitelně patří k naší současnosti. Kvalitně navržená a provedená tepelná izolace obvodového zdiva zásadně ovlivňuje užitné, provozní,…

Nový štěrbinový odvodňovací žlab MEADRAIN PG 1500.SC od společnosti MEA MEISINGER byl speciálně vyvinut pro zachycení vody z krytých parkovacích ploch s konstrukční výškou…

Komplexní nabídka společnosti Sanitec byla od února rozšířena o instalační modul Kolo, který je určen pro montáž všech druhů závěsných klozetů KOLO a KERAMAG. Zaručuje rychlou a…
Článek přímo navazuje na předchozí příspěvek, který se věnoval zkoumání fyzického stavu materiálů jednotlivých funkčních vrstev, přičemž hlavní pozornost byla zaměřena na…

Společnost Primalex vyrábí celou škálu fasádních barev, které se dělí na akrylátové, silikátové a silikonové. Jejich použití je široké - od novostaveb po historické objekty.…

Na pracovištích soupeří o naši pozornost mnoho zdrojů zvuku. Zároveň se od nás očekává efektivita a kvalitní práce. Dobrá akustika je součást kvalitního pracovního prostředí,…